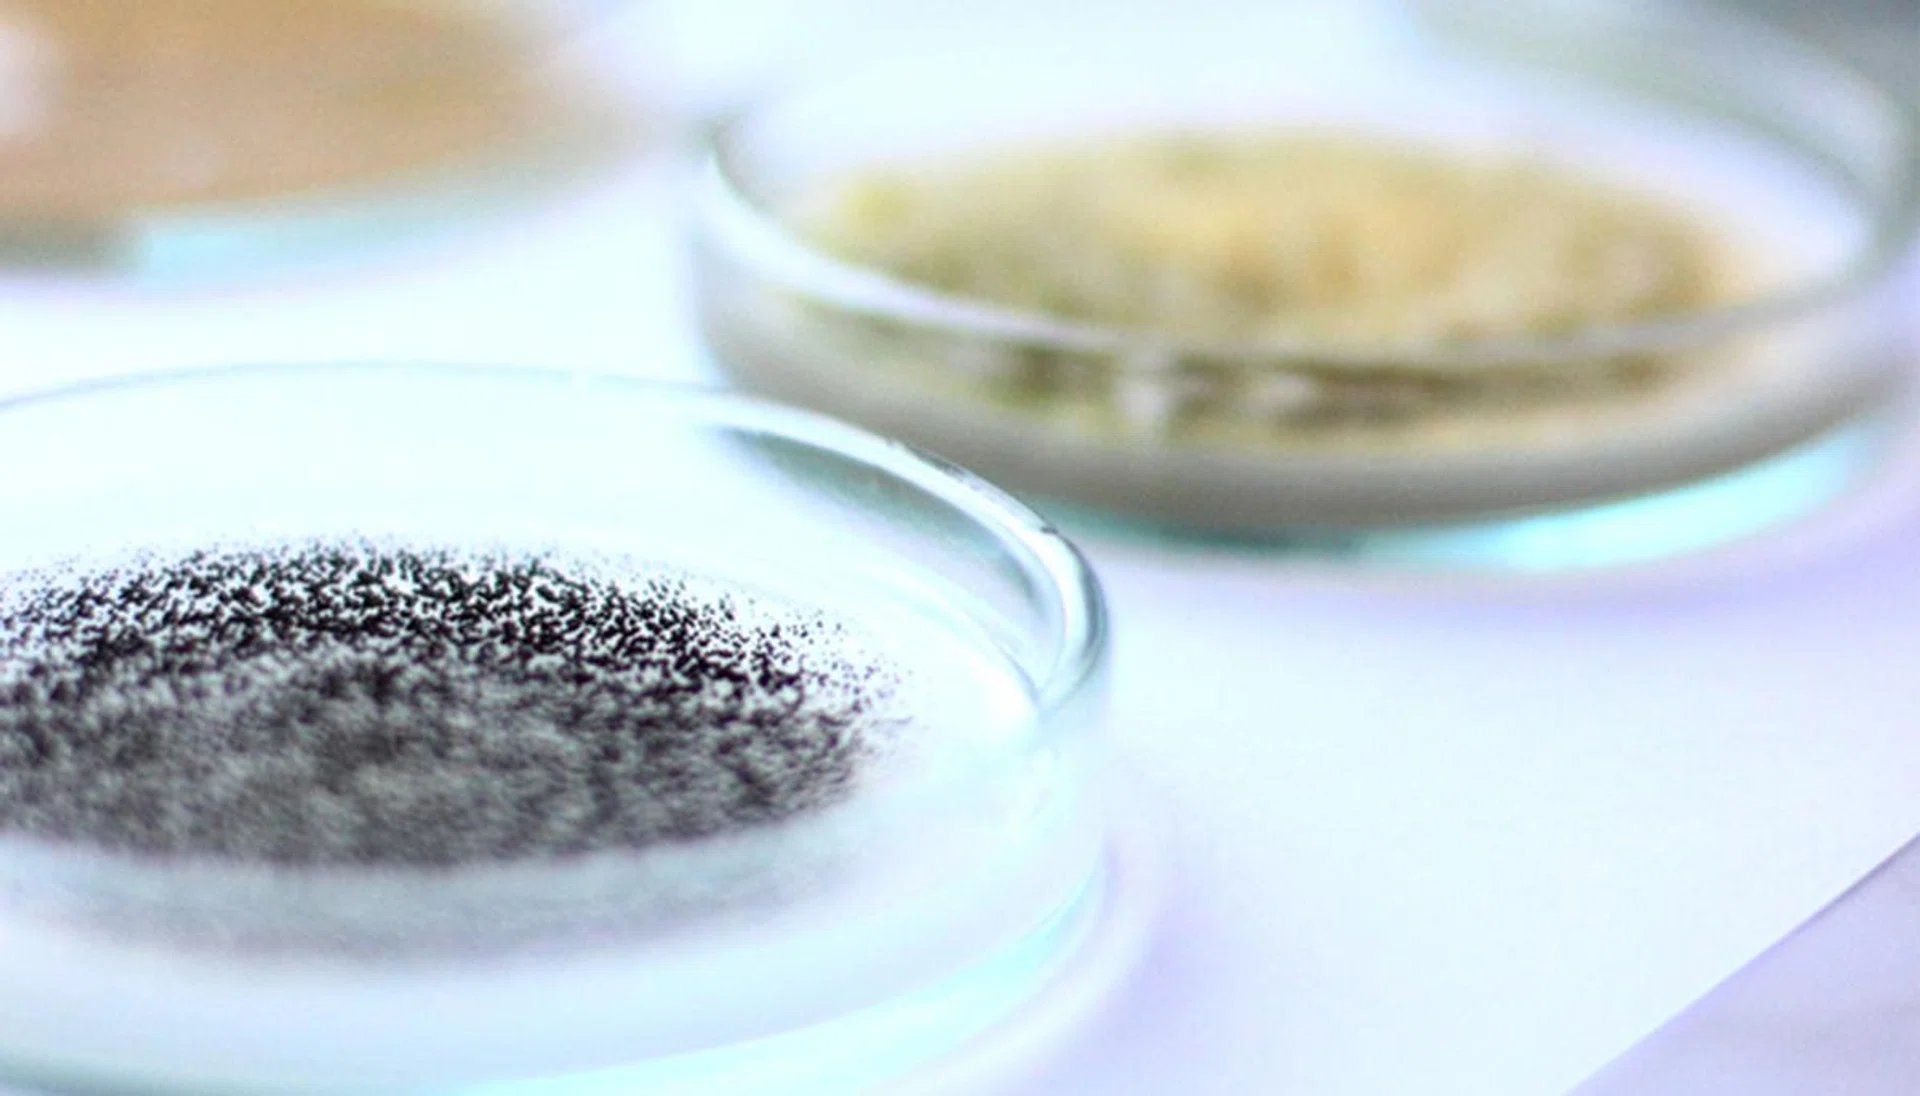

Feed Your Skin The Essential Nutrients It Needs With These Nourishing Skincare Products
Take care of your body’s largest organ – your skin – by ensuring it gets all the nutrients it needs with these essentials from Clair® Skin Solutions:
Intense Moisture
Strengthen your first line of defence against premature ageing with Clair® Skin Solutions Hydro Firming Serum ($72 for 30 ml). It deeply nourishes and firms skin, and makes it resilient with a potent blend of hyaluronic acids – known to hold 1,000 times its weight in moisture – patented oats extract as natural skin “sugars” and botanical extracts.
Firm And Hydrate
Formulated with collagen-boosting yeast and moisture-retaining hyaluronic acids and amino acids, Clair® Skin Solutions Hydro Firming Moisture Lotion ($62 for 30 ml) infuses skin with long-lasting hydration. Its non-comedogenic formula is designed to soothe skin distressed by acid peels or laser procedures.
Sun Protection
Never head outdoors without a good sunblock like Clair® Skin Solutions Ultra-Light Sunblock SPF50+ PA++++ ($56 for 30 ml) for company. This non-greasy fast-absorbing skin protector staves off harmful UV rays with its specialised encapsulated UV filters that provide maximum coverage without clogging up your pores. It's the secret to keeping your complexion youthful-looking.
Clair® Skin Solutions is available at OG People’s Park Metro Centrepoint. For more information, visit www.dermabiz.com.sg
Brought to you by Clair® Skin Solutions
Here’s The Best Way To Shield Your Skin Against The Sun’s Harmful UV Rays